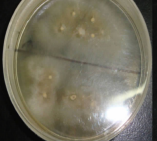
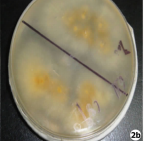

표재성 곰팡이균(진균)인 사상균이 피부의 가장 바깥인 각질층, 손발톱, 머리카락에 감염 및 증식되어 발생하는 질병
*”백선증”이라고도 함

|

|
|
|
|
- 무좀균 도말검사 - |
|

|
|
- 현미경으로 본 무좀균 - |

|

|

|

|

|

|

|

|

|

|

|

|

|

|

|

|
*스테로이드과다 사용으로 발병

|

|
습진, 한포진, 손발농포병
*습진, 한포진 등의 피부병에 무좀은 기본적으로 동반됨






- 유형별, 치료율, 무좀균음성율, 치료기간, 재발율
| 유형 | 치료율(%) | 완치율(%) | 치료기간(일) | 재발율 |
|---|---|---|---|---|
| 발무좀 | 97 | 100 | 10 ~ 20 | 거의 없음 |
| 손무좀 | 97 | 100 | 7 ~ 21 | 거의 없음 |
| 손발톱무좀 | 90 | 100 | 15 ~ 60 | 거의 없음 |
| 생식기 사타구니 백선 | 91 | 100 | 7 ~ 42 | 거의 없음 |
| 몸(체부),엉덩이무좀 | 95 | 100 | 6 ~ 12 | 거의 없음 |
| 얼굴무좀 | 97 | 100 | 6 ~ 12 | 거의 없음 |
| 두피무좀 | 98 | 100 | 4 ~ 30 | 거의 없음 |
*치료율, 치료기간, 재발율은 평균이며 환자에 따라 차이가 있을 수 있음
*재발율은 3%이내이며 치료후 5개월~1년 관찰추적결과임
*무좀균음성율은 치료후 균배양검사로 무좀균 발견되지 않은 것을 말함
- 효과시작싯점: 치료 4-6일이후
- 안전성
외용치료중인 일부 환자에서 약한 피부소양증이 있었으며 한약복용환자의 간, 신장독성 및 부작용 없었음
*무좀상태에 따라 외용한약, 복용한약, 침치료 함
*독성이 강한 치료 피함
*적은 양의 무좀균으로 재발, 재감염 될 수 있음